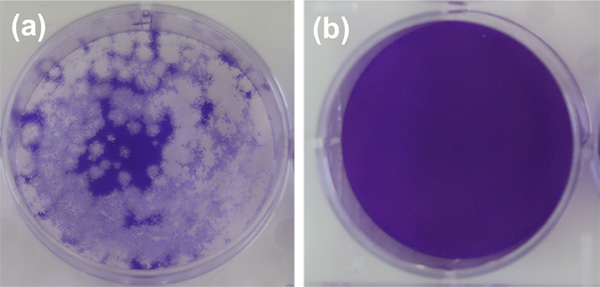

東工大ニュース
東工大ニュース
公開日:2021.03.05
東京工業大学 物質理工学院 材料系の中島章教授、伊東拓朗大学院生(修士課程1年)らは、神奈川県立産業技術総合研究所(研究開発部 抗菌・抗ウイルス研究グループ)、奈良県立医科大学(微生物感染症学講座 中野竜一准教授 矢野寿一教授)との共同研究で、新型コロナウイルス(SARS-CoV-2)に対して極めて高い不活化[用語1]効果を示す複合酸化物を開発した。
従来の無機系抗ウイルス材料には、銅(Cu)などの金属系、酸化チタン(TiO2)などの光触媒系、その他(酸化カルシウム(CaO)など)があるが、酸化による抗ウイルス活性の低下や色の変化(金属系)、光の必要性(光触媒系)、土壌のアルカリ化(CaO)等の問題点があり、これらの問題点を克服して高い活性を有する抗ウイルス材料が望まれていた。
中島教授らの研究グループは、比較的安価な希土類であるセリウム(Ce)と、抗菌活性が知られているモリブデン(Mo)に着目し、これらの複合酸化物[用語2]であるγ-Ce2Mo3O13(CMO)を水熱合成法[用語3]により作製した。その結果、CMOがSARS-CoV-2に対して極めて高い不活化効果を示すことを見出した。同様の高い抗ウイルス活性は、他のエンベロープ型ウイルス[用語4]に対しても確認されており、本成果は様々なウイルスに対して適用できる可能性がある。また、ワクチン頼みのウイルス対策からのゲームチェンジにつながる新たな技術として期待される。
本成果は2月11日付(現地時間)でオランダの科学誌「Materials Letters」にオンライン掲載された。
現在、新型コロナウイルス(SARS-CoV-2)感染症(COVID-19)が世界中に広がっており、人類の大きな脅威となっている。そのため、ウイルス感染の予防や拡大抑制は喫緊の課題となっており、抗ウイルス材料の必要性や需要が高まっている。有機系の抗ウイルス材料に比べ、無機系の抗ウイルス材料は研究の歴史は浅いが、比較的広い温度範囲で様々なウイルスに対して効果を発揮するものが多いことや、ウイルスが耐性を獲得しにくいこと等の理由から、近年徐々に研究が増加している。無機系の抗ウイルス材料には様々なものがあり、Cuなどの金属イオンが高い抗ウイルス活性を示すことはよく知られているが、酸化が色の変化や活性の低下を招くことが問題となっている。また、TiO2等の光触媒材料も抗ウイルス材料であるが、光照射を必要とするため、暗所では活性を発現しない。石灰や酸化亜鉛にも抗ウイルス活性が知られているが、アルカリ化や活性の経時劣化、活性の低さ等の問題点がある。このため、これらの問題点を克服する新規の抗ウイルス材料の開発が求められていた。
東京工業大学の中島章教授を中心とする研究グループは2019年、自己撥水性が報告されている酸化ランタンと、抗菌活性が報告されている酸化モリブデンを組み合わせた複合酸化物であるLa2Mo2O9(LMO)の抗菌・抗ウイルス活性を調べた。その結果LMOは、暗所において、細菌(大腸菌と黄色ブドウ球菌)とウイルス(バクテリオファージ[用語5]QβとΦ6)に対して高い抗菌・抗ウイルス活性を発現する特徴的な酸化物であること、またインフルエンザウイルスが感染するMDCK細胞に対する毒性が少ないことを明らかにした。しかしながらLMOは、大腸菌、黄色ブドウ球菌、Qβに対する活性に比べ、SARS-CoV-2と同様のエンベロープ型ウイルスであるΦ6に対する活性が低く、この活性を高めることが課題となっていた。
中島教授らはこの課題を検討する過程で、LMOのランタン(La)の一部を同じ希土類であるセリウム(Ce)に置き換えることで、Φ6に対する活性が高まることを見出し、LMOのLaをすべてCeに置換した複合酸化物の合成を試みた。Laとは異なりCeは複数の価数を持つことから、Ceとモリブデン(Mo)を含む複合酸化物では作製条件のわずかな違いで様々な結晶相が出現し、単相粉[用語6]が得られにくい。中島教授らは、合成条件や出発原料を変更しながら、CMOの単相粉の作製実験を繰り返して適切な条件を検討した結果、水熱合成法によりモリブデン酸セリウム(γ-Ce2Mo3O13、CMO)の単相粉の合成に成功した。そしてこのCMOが、バクテリオファージΦ6だけでなく、同じエンベロープ型ウイルスであり、ヒトに感染するSARS-CoV-2に対しても極めて高い抗ウイルス活性を発現する(図1、図2参照)ことを見出した。さらにLMOと同様、MDCK細胞に対する毒性も少なかった。この抗ウイルス機構には、溶出したモリブデン酸イオンとともに、微量のセリウムイオンが関与していることが示唆される。

図1. 新型コロナウイルス(SARS-CoV-2)の生存量の変化
縦軸はウイルスの生存量の対数表示。測定はISO規定のフィルム密着法。ガラス上のウイルス量は変化しないが、LMOにCeを10%添加したLCMOはウイルス濃度が6時間で約1.5ケタ(約1/30に)低下する。 CMO粉末では4時間でウイルス濃度は4ケタ以上(1/10000以下に)低下することが分かる。この活性はMoO3よりも高く、Ceと組み合わせることの効果が分かる。
図2. 図1の実験での4時間の時点での(a)ガラスと、(b)CMOの違い
宿主細胞が正常に生きていると青色に染色されるが、ウイルスが存在すると宿主細胞が死滅し染色されないため、透明なプラークが形成される。ガラス上ではウイルスが存在し、大量のプラークが存在するが、CMOにはプラークがまったくなく、ウイルスが検出限界まで不活化していることが分かる。
ワクチンが開発されて普及するまでの間、経済活動や社会活動を継続するためには、感染の予防や拡大抑制に関する技術が、治療法の確立やワクチンの開発と同じくらい重要である。本研究成果は、ワクチン頼みのウイルス対策からのゲームチェンジに新たな道を開くだけでなく、近年わが国で頻発する大規模自然災害等の被災地での衛生環境確保の面においても有効な技術となる可能性がある。LMOはすでに試作が始まっているが、今回開発したCMOも速やかに試作を開始し、早急な実用化を目指す。
用語説明
[用語1] 不活化 : ここではウイルスが宿主に感染する能力を失わせて死滅させることをいう。
[用語2] 複合酸化物 : 2種以上の酸化物が組み合わさり、O2-の最密充填の隙間にそれぞれの金属イオンが平等なイオン格子を形成したもの。
[用語3] 水熱合成法 : 高温高圧の熱水の存在下で行われる化合物の合成方法。常温常圧では水に溶けない物質も容易に溶解するため、通常は得られないような物質の合成、成長が可能。圧力釜と同じ原理であり、密閉容器中に出発物質と水を入れ、容器を密閉したまま加熱することで生成物を得る方法である。
[用語4] エンベロープ型ウイルス : ウイルスの構造は、カプシド(ウイルスゲノムを取り囲むタンパク質の殻)にエンペローブ(一部のウイルスに見られる膜状の構造のこと)が覆うインフルエンザウイルスや新型コロナウイルスのような構造と、カプシドのみのノロウイルスのような構造の2種類に大別される。前者の構造を持つウイルスをエンベロープ型ウイルスと呼ぶ。
[用語5] バクテリオファージ : 細菌に感染するウイルスの総称。バクテリオファージQβはエンベロープを持たないが、バクテリオファージΦ6はエンベロープを持つ。
[用語6] 単相粉 : 単一結晶相からなる粉末のこと。
論文情報
掲載誌 : |
Materials Letters |
論文タイトル : |
Preparation of cerium molybdates and their antiviral activity against bacteriophage Φ6 and SARS-CoV-2 |
著者 : |
Takuro Ito, Kayano Sunada, Takeshi Nagai, Hitoshi Ishiguro, Ryuichi Nakano, Yuki Suzuki, Akiyo Nakano, Hisakazu Yano, Toshihiro Isobe, Sachiko Matsushita, Akira Nakajima |
DOI : |
お問い合わせ先
東京工業大学 物質理工学院 材料系
教授 中島章
E-mail : nakajima.a.aa@m.titech.ac.jp
Tel : 03-5734-2524 / Fax : 03-5734-2525
神奈川県立産業技術総合研究所 抗菌・抗ウイルス研究グループ
石黒斉、砂田香矢乃
E-mail : sks@newkast.or.jp
Tel : 044-280-1181 / Fax : 044-280-1182
奈良県立医科大学 微生物感染症学講座
准教授 中野竜一
E-mail : rnakano@naramed-u.ac.jp
Tel : 0744-22-3051
取材申し込み先
東京工業大学 総務部 広報課
E-mail : media@jim.titech.ac.jp
Tel : 03-5734-2975 / Fax : 03-5734-3661
神奈川県立産業技術総合研究所 研究開発部
E-mail : sks@newkast.or.jp
Tel : 044-819-2031 / Fax : 044-819-2026
奈良県立医科大学 研究推進課
E-mail : sangaku@naramed-u.ac.jp
Tel : 0744-22-3051